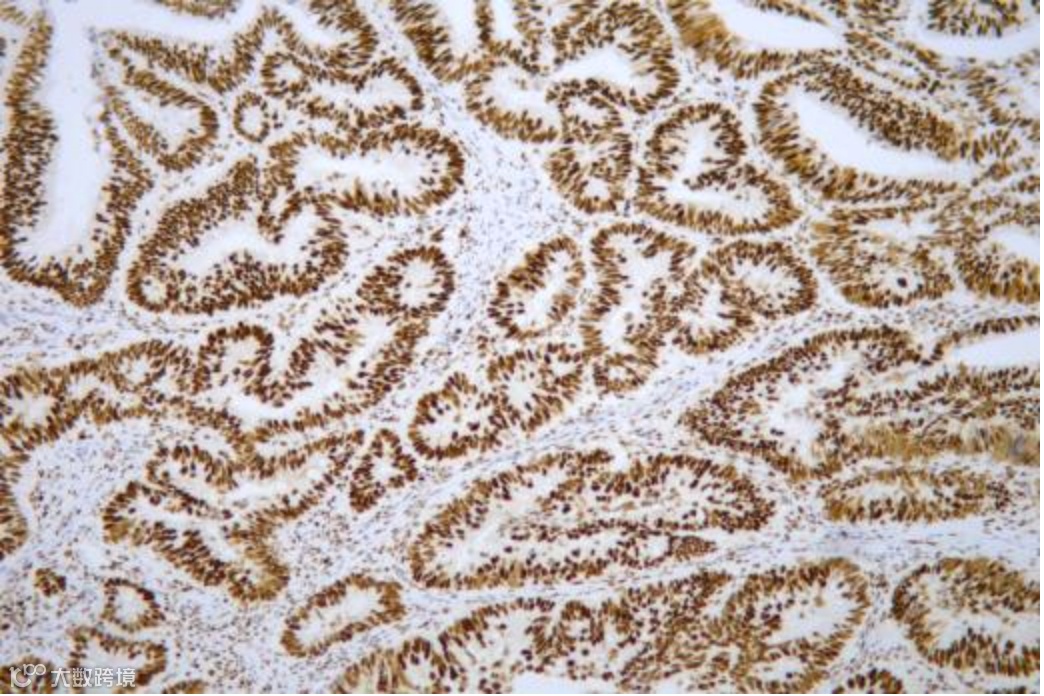

*'Optimal'为NordiQC对染色结果评价的最高等级,意味着在测试的组织中,染色结果被认为是完美的或接近完美的。


TTF-1 达泰生物 DTBL0225201 染色效果图

MSH2 达泰生物 DTBL0216901 染色效果图


MSH2 达泰生物DTBL0220101 染色效果图


CD10 达泰生物 DTBL0204001 染色效果图
NordiQC将染色结果划分为Optimal(优秀)-Good(良好)-Borderline Staining(临界)- Poor Staining(差)四个等级, 其中优秀、良好被认为是合格的染色结果。‘Optimal’为NordiQC对染色结果评价的最高等级,意味着在测试的组织样本值中,染色结果被认为是完美的或接近完美的。在NordiQC的评估中,染色结果的免疫反应性、染色强度、染色背景及整体信-噪比均将被考核。优秀的染色结果是高标准的试剂和严格染色流程的匹配,两方面缺一不可。
达泰生物致力于开发灵敏度高,特异性强,稳定性好的免疫组化抗体,达泰生物建立有成熟完善抗体自主研发体系,为优越的免疫组化抗体性能保驾护航。本次参评的MSH2、CD10、PAX8、TTF-1抗体原料均为达泰生物自主研发,产品经过充分的染色性能评估、体系优化及稳定性考察,在本轮测试表现优异。目前,达泰生物拥有经过充分验证的免疫组化抗体产品超过270种,辅助试剂、免疫显色试剂、病理染色液超过40种。
关于NordiQC
北欧免疫组织化学质量控制(NordiQC)组织是国际公认的权威病理室间质评机构。
NordiQC通过组织系列的免疫组化测试、提供推荐方案的染色示例、提供组织对照和其他相关信息(包括表位描述和染色方案的方案参数)等方式,提高免疫组化的质量,扩大免疫组化的临床应用。
免疫组化抗体目录

注:文章来源于赢享分子诊断公众号



